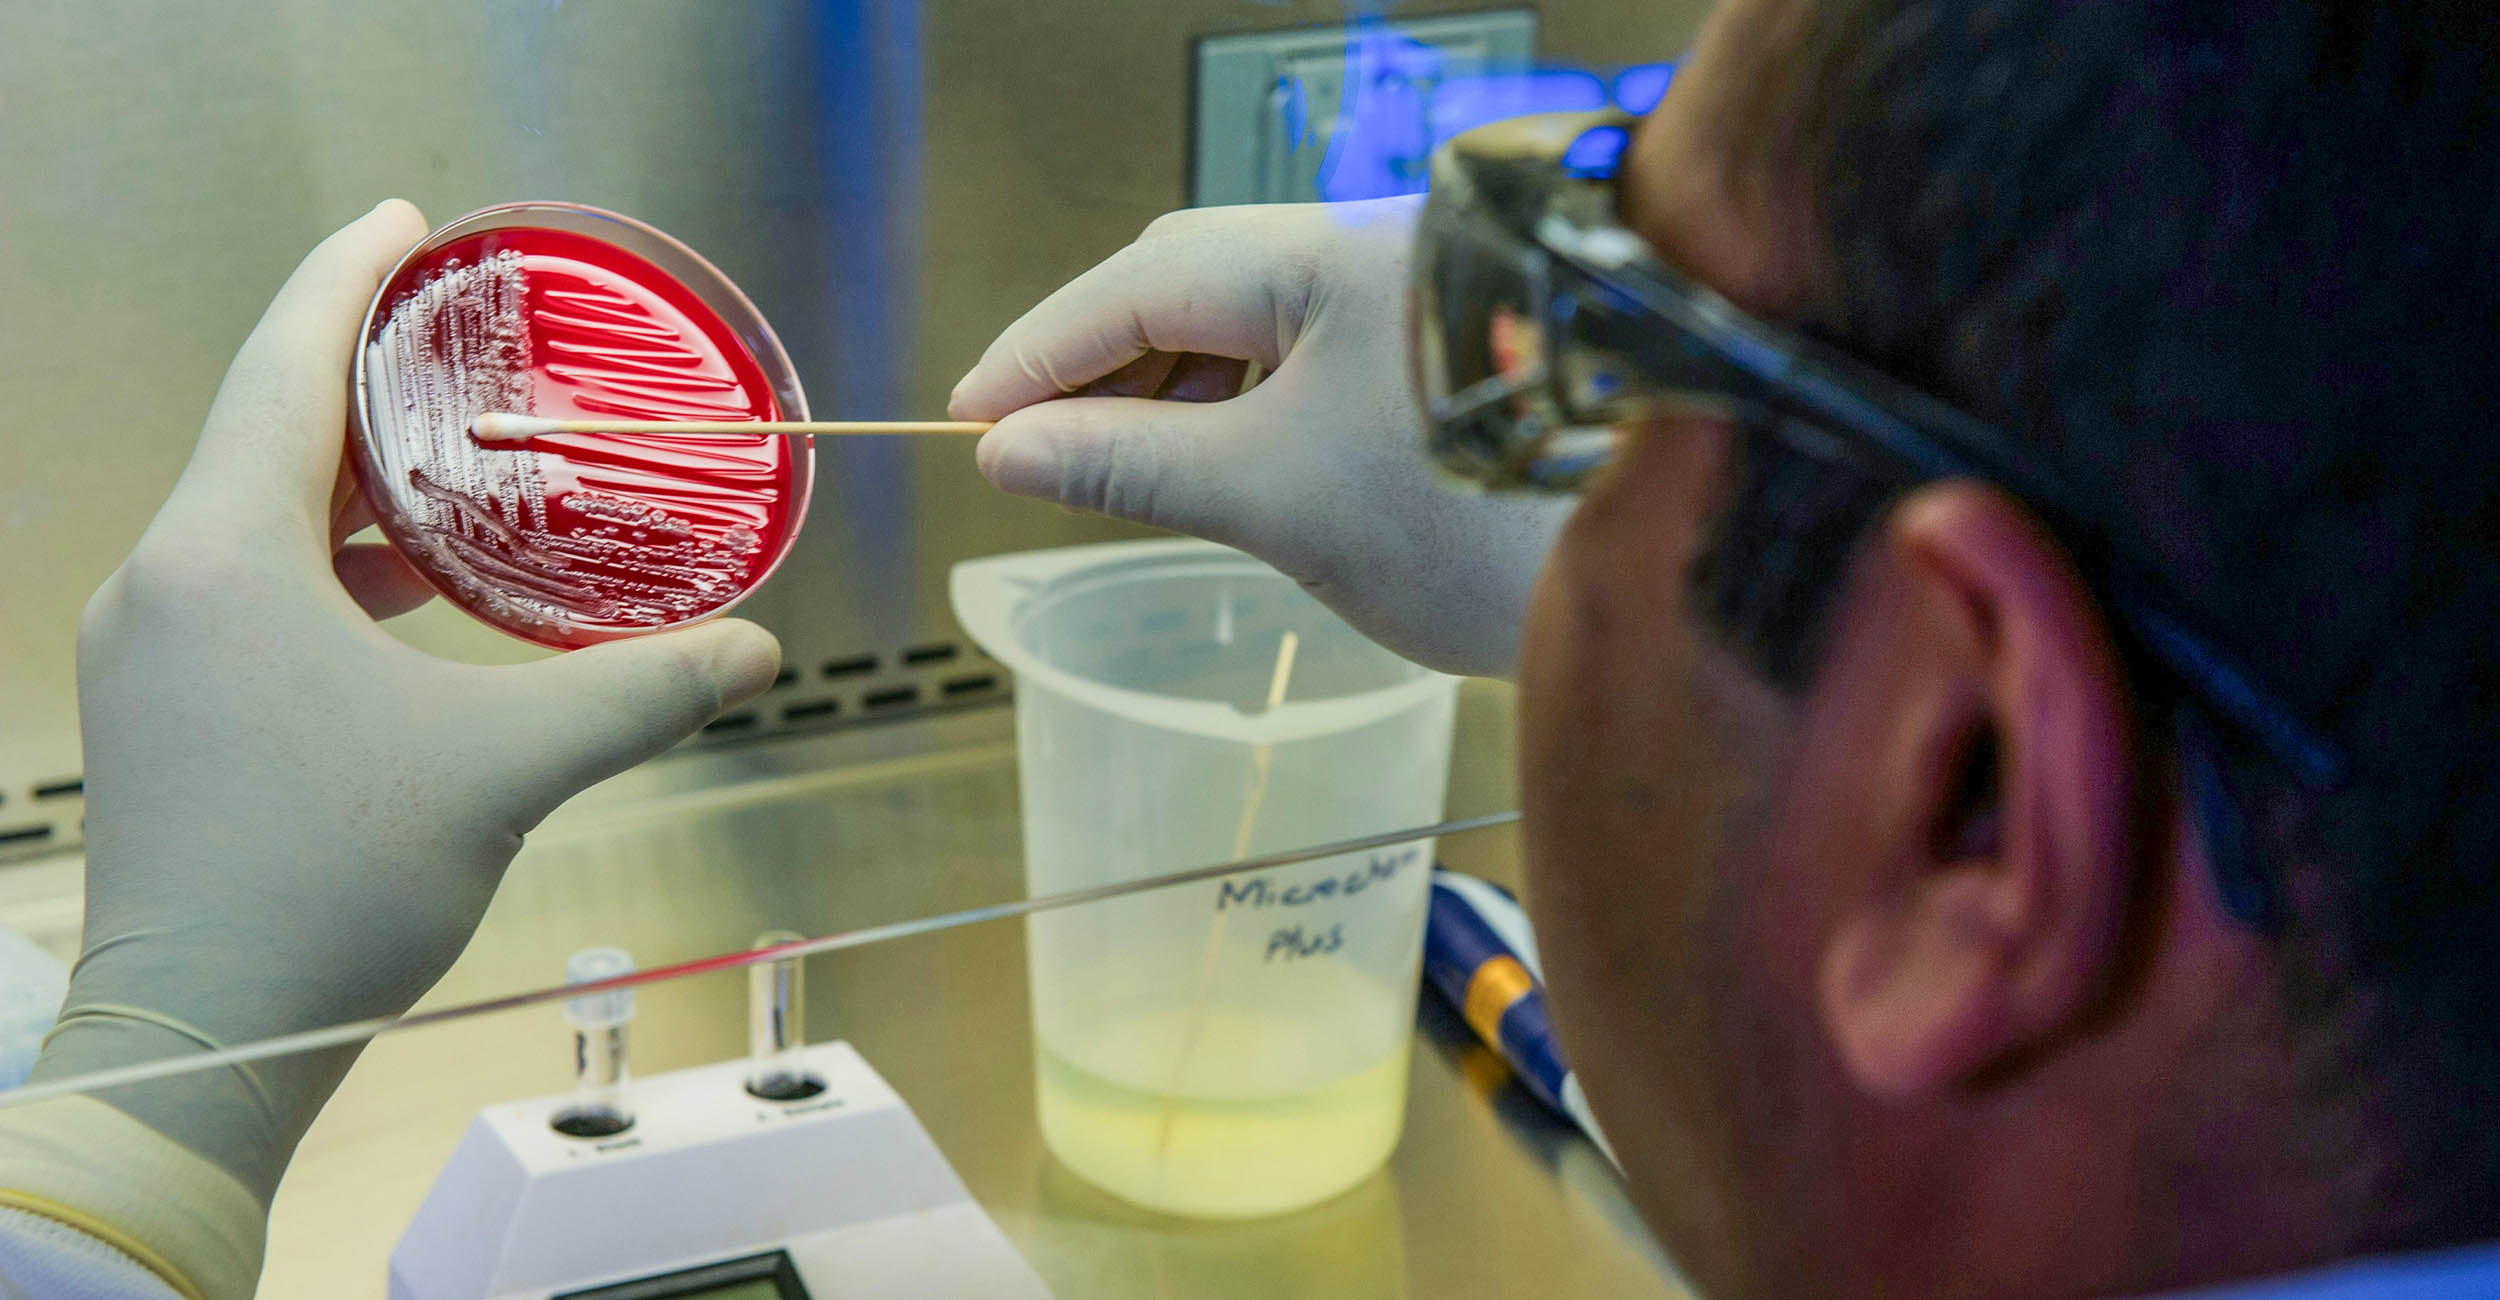
A man with brown hair and wearing a white lab coat and white gloves who is swabbing a red substance in a petri dish. The view is from behind the man's head.

Food and Agricultural Products Center announces food microbiology workshop
Wednesday, July 10, 2024
Media Contact: Emma Grace Nowotny | Food and Agricultural Products Center Communications Services | 405-744-0442 | emma.grace.nowotny@okstate.edu
Oklahoma State University’s Robert M. Kerr Food and Agricultural Products Center is set to host a Food Microbiology Workshop from 8 a.m. to 5 p.m. on Oct. 2 and 8 a.m. to noon on Oct. 3.
The Food Microbiology Workshop is open to the public and will feature industry experts on the intricacies of ensuring food safety through microbiological analysis. Participants will engage in comprehensive sessions covering various aspects of food microbiology, from regulatory compliance to practical laboratory exercises.
“Food microbiological testing needs can vary within the different production types. From testing methods to swabbing techniques, we are providing a workshop that covers the needs of the state's food manufacturing facilities,” said Peter Muriana, a workshop instructor and Food and Agricultural Products Center food microbiologist. “In the planning stages, we conducted a survey, and as a result, we were able to construct the workshop around the requests of our constituents.”
The workshop is designed to create an immersive and educational experience to enhance participants’ understanding and skills in food microbiology for the safety and quality of food products.
The cost is $425 per participant, and lunch will be provided. Registration is limited to 20 participants.
For more information and registration, contact Karen Smith, workshop coordinator, at karenl.smith@okstate.edu or call 405-744-6277.